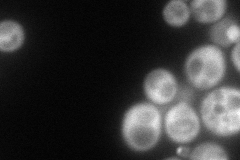
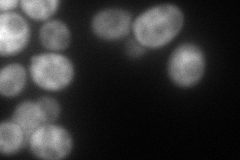
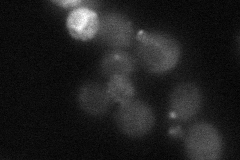
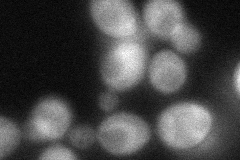
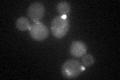

View description
GTPase-activating protein (GAP) for yeast Rab family members, involved in ER to Golgi trafficking; exhibits GAP activity toward Ypt1p that is stimulated by Gyl1p, also acts on Sec4p; interacts with Gyl1p, Rvs161p and Rvs167p
Localization:
Intensity:
Fold change:
Significance:
-
C’ GFP library in SD

bud neckN/A -
N' NOP1pr-GFP in SD
cytosol,bud126.123 -
N' TEF2pr-mCherry in SD
cytosol124.546 -
N' NATIVEpr-GFP in SD
punctate,bud neck21.3793 -
N' TEF2pr-VC and Cyto-VN in SD
below threshold63.3991 -
C’ GFP library in SD+DTT
bud neck22.740.98No -
C’ GFP library in SD+H2O2

bud neck24.261.04No -
C’ GFP library in Starvation Media

bud neck21.630.93No -
C’ GFP library on the background of Pup2-DaMP

bud neck -
C’ GFP library on the background of CCT mutant

bud neck23.28721.00575No
